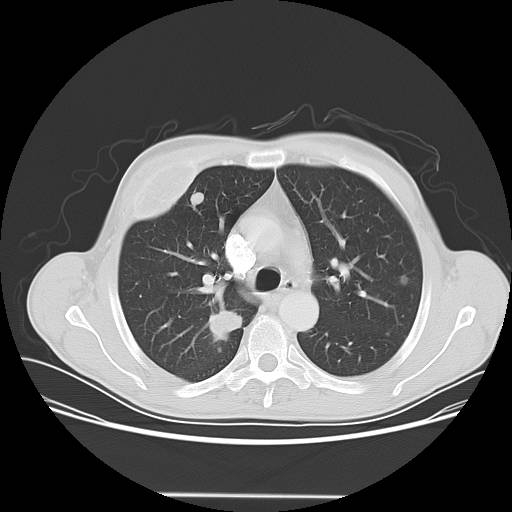
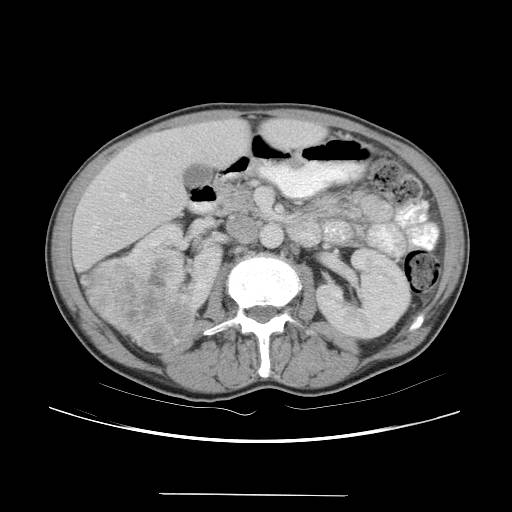

IMPRESSION:
1. Likely renal cell carcinoma with multiple metastases to lung, right
3rd rib, and likely right iliac. There is no definite invasion of
adjacent organs or the vasculature.

IMPRESSION:
1. Likely renal cell carcinoma with multiple metastases to lung, right
3rd rib, and likely right iliac. There is no definite invasion of
adjacent organs or the vasculature.